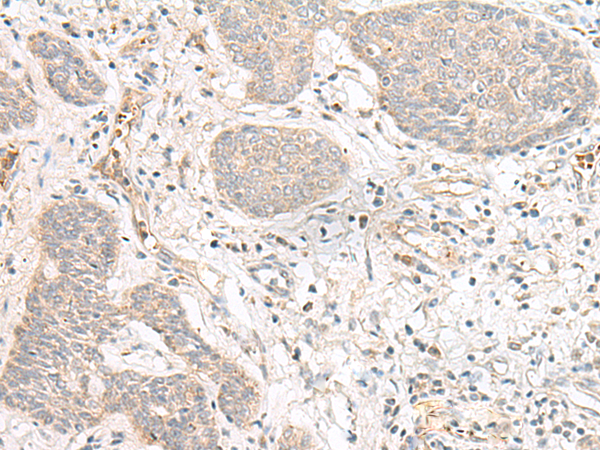

-
分类: 科研抗体货号: P13403别名: RFRP; C7orf9应用: IHC反应种属: Human
-
分类: 科研抗体货号: P13401别名: FCRN; alpha-chain应用: WB,IHC反应种属: Human
-
分类: 科研抗体货号: P13420别名: TOCA1; C1orf39应用: WB,IHC反应种属: Human, Mouse, Rat
-
分类: 科研抗体货号: P13400别名: FBW6; FBW8; FBX29; FBXW6; FBXO29应用: IHC反应种属: Human
-
分类: 科研抗体货号: P13419别名: ABPA; ABPL; FLN2; MFM5; MPD4; RCM5; CMH26; ABP-280; ABP280A应用: WB,IHC反应种属: Human, Mouse, Rat
-
分类: 科研抗体货号: P13399别名: Fbx45应用: IHC反应种属: Human, Mouse, Rat
-
分类: 科研抗体货号: P13418别名: C1orf188应用: IHC反应种属: Human
-
分类: 科研抗体货号: P13398别名: FBX14; Fbx31; MRT45; FBXO14; pp2386应用: IHC反应种属: Human, Mouse, Rat
-
分类: 科研抗体货号: P13417别名: CCDC44应用: WB反应种属: Human, Mouse, Rat
-
分类: 科研抗体货号: P13396别名: Fbl16; C16orf22; c380A1.1应用: IHC反应种属: Human, Mouse, Rat

鄂公网安备42018502007531号
鄂公网安备42018502007531号

